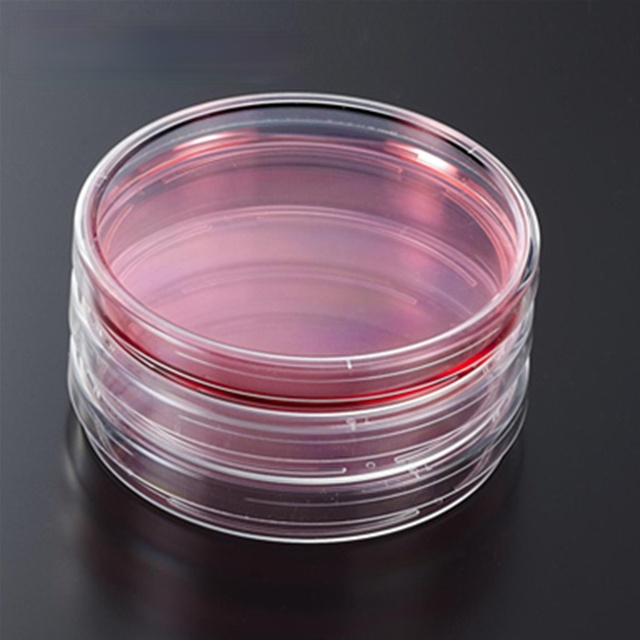

Zhengzhou Chuangsheng Biological Engineering Co., Ltd.
Найдено товаров -

250 мл 500 мл пластиковая лабораторная Стерильная центрифуга для реагентов
- Категории:
- Поставщик: Zhengzhou Chuangsheng Biological Engineering Co., Ltd.
US $121.00
На складе

Medispan входа в лаборатории стерильные 6 хорошо 24 хорошо 96 хорошо Культура клеток плиты
- Категории: Lab Drying Equipment
- Поставщик: Zhengzhou Chuangsheng Biological Engineering Co., Ltd.
US $49.50
На складе

Sterilized Nutrient Petri Dish With Agar for Growing Bacteria
- Категории:
- Поставщик: Zhengzhou Chuangsheng Biological Engineering Co., Ltd.
US $56.72
На складе